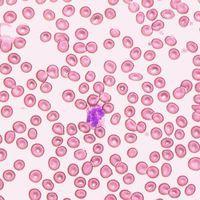
紅細胞6-磷酸葡萄糖脫氫酶(G6PD)缺陷症

疾病名稱
紅細胞6-磷酸葡萄糖脫氫酶(G6PD)缺陷症
疾病別名
蠶豆病
疾病分類
血液科
疾病概述
紅細胞6-磷酸葡萄糖脫氫酶(G6PD)缺陷症俗稱“蠶豆病”,是一種以黃疸、貧血、血紅蛋白尿為主要特徵的溶血性反應性疾病。患者在進食蠶豆(接觸蠶豆花粉)或某些藥物後,可導致大量紅細胞破裂,出現溶血性貧血,同時溶血產生大量的血紅蛋白可從尿中排出,使尿呈醬油色,其代謝物膽紅素則使患者出現黃疸。
疾病描述
紅細胞6-磷酸葡萄糖脫氫酶(G6PD)缺陷症俗稱“蠶豆病”,是一種以黃疸、貧血、血紅蛋白尿為主要特徵的溶血性反應性疾病。患者在進食蠶豆(接觸蠶豆花粉)或某些藥物後,可導致大量紅細胞破裂,出現溶血性貧血,同時溶血產生大量的血紅蛋白可從尿中排出,使尿呈醬油色,其代謝物膽紅素則使患者出現黃疸。
症狀體徵
注意血壓、黃疸、肝脾情況。
疾病病因
注意是否於食蠶豆後(幾小時至1~2d)突然發熱、腹痛、黃疸、醬油色尿,甚至休克、尿閉和急性腎功能衰竭。了解是否服過具有氧化性能的藥物(如抗瘧藥、磺胺藥、解熱鎮痛藥、呋喃類藥物等)及樟腦丸中毒。有無糖尿病酸中毒、低血糖以及病毒或細菌感染等誘發因素。
病理生理
具體發病機制不是很清楚。
診斷檢查
需作紅細胞計數及血紅蛋白量、網織紅細胞計數、骨髓象。血紅蛋白尿測定,高鐵血紅蛋白還原試驗,紅細胞G6PD洗脫試驗,變性珠蛋白小體生成試驗,有條件作G6PD定量測定。血清間應膽紅素及尿膽原測定。急性溶血時作血清游離血紅蛋白及結合珠蛋白測定。
治療方案
1.按血液系統疾病護理常規。
2.給予高熱量軟質飲食,充分飲水。出現血紅蛋白尿時應鹼化尿液。
3.去除誘因,禁食蠶豆及禁用可能誘發本病的藥物。
4.宜予靜脈輸入右旋糖酐40。並發急性腎功能衰竭時,應注意水與電解質平衡。如需輸血,選擇供血者時應先作G6PD過篩檢查,並應避免親屬供血。
預後及預防
無特殊預防方式。
特別提示
1、此種病症常見於兒童,3歲以下占70%,男性患者占90%。成人患者比較少見,但也有少數病人至中年或老年才首次發病。由於G6PD缺乏屬遺傳性,所以40%以上的病例有家族史。
2、本病常發生於初夏蠶豆成熟季節。絕大多數病人因進食新鮮蠶豆而發病。本病因南北各地氣候不同而發病有遲有早。
3、治療注意:
(1)給予高熱量軟質飲食,多飲水。
(2)去除誘因,如蠶豆、抗瘧藥、磺胺類藥、解熱鎮痛藥及注意避免某些疾病。
(3)並發急性腎功能衰竭時,須注意水電解質平衡。
(4)給予輸血,選擇供血者應先做G6PD過篩檢查,並應避免親屬供血。
4、紅細胞6-磷酸葡萄糖脫氫酶(G6PD)缺陷症俗稱“蠶豆病”,是一種以黃疸、貧血、血紅蛋白尿為主要特徵的溶血性反應性疾病。